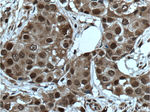
Cyclin E2 Antibody in Immunohistochemistry (Paraffin) (IHC (P))
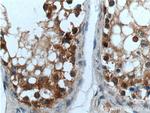
Cyclin E2 Antibody in Immunohistochemistry (Paraffin) (IHC (P))
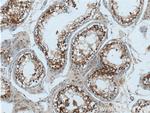
Cyclin E2 Antibody in Immunohistochemistry (Paraffin) (IHC (P))

Search
Proteintech
Cyclin E2 Polyclonal Antibody
{{$productOrderCtrl.translations['antibody.pdp.commerceCard.promotion.promotions']}}
{{$productOrderCtrl.translations['antibody.pdp.commerceCard.promotion.viewpromo']}}
{{$productOrderCtrl.translations['antibody.pdp.commerceCard.promotion.promocode']}}: {{promo.promoCode}} {{promo.promoTitle}} {{promo.promoDescription}}. {{$productOrderCtrl.translations['antibody.pdp.commerceCard.promotion.learnmore']}}
产品信息
11935-1-AP
种属反应
已发表种属
宿主/亚型
分类
类型
抗原
偶联物
形式
浓度
规格
纯化类型
保存液
内含物
保存条件
运输条件
产品详细信息
Immunogen sequence: MSRRSSRLQ AKQQPQPSQT ESPQEAQIIQ AKKRKTTQDV KKRREEVTKK HQYEIRNCWP PVLSGGISPC IIIETPHKEI GTSDFSRFTN YRFKNLFINP SPLPDLSWGC SKEVWLNMLK KESRYVHDKH FEVLHSDLEP QMRSILLDWL LEVCEVYTLH RETFYLAQDF FDRFMLTQKD INKNMLQLIG ITSLFIASKL EEIYAPKLQE FAYVTDGACS EEDILRMELI ILKALKWELC PVTIISWLNL FLQVDALKDA PKVLLPQYSQ ETFIQIAQLL DLCILAIDSL EFQYRILTAA ALCHFTSIEV VKKASGLEWD SISECVDWMV PFVNVVKSTS PVKLKTFKKI PMEDRHNIQT HTNYLAMLCM ISSHV (1-374 aa encoded by BC020729)
靶标信息
This gene encodes WW domain-containing binding protein 4. The WW domain represents a small and compact globular structure that interacts with proline-rich ligands. This encoded protein is a general spliceosomal protein that may play a role in cross-intron bridging of U1 and U2 snRNPs in the spliceosomal complex A.
仅用于科研。不用于诊断过程。未经明确授权不得转售。
生物信息学
蛋白别名: CYCE2; G1 cyclin; G1/S-specific cyclin-E2
基因别名: CCNE2; CYCE2
UniProt ID: (Human) O96020
Entrez Gene ID: (Human) 9134